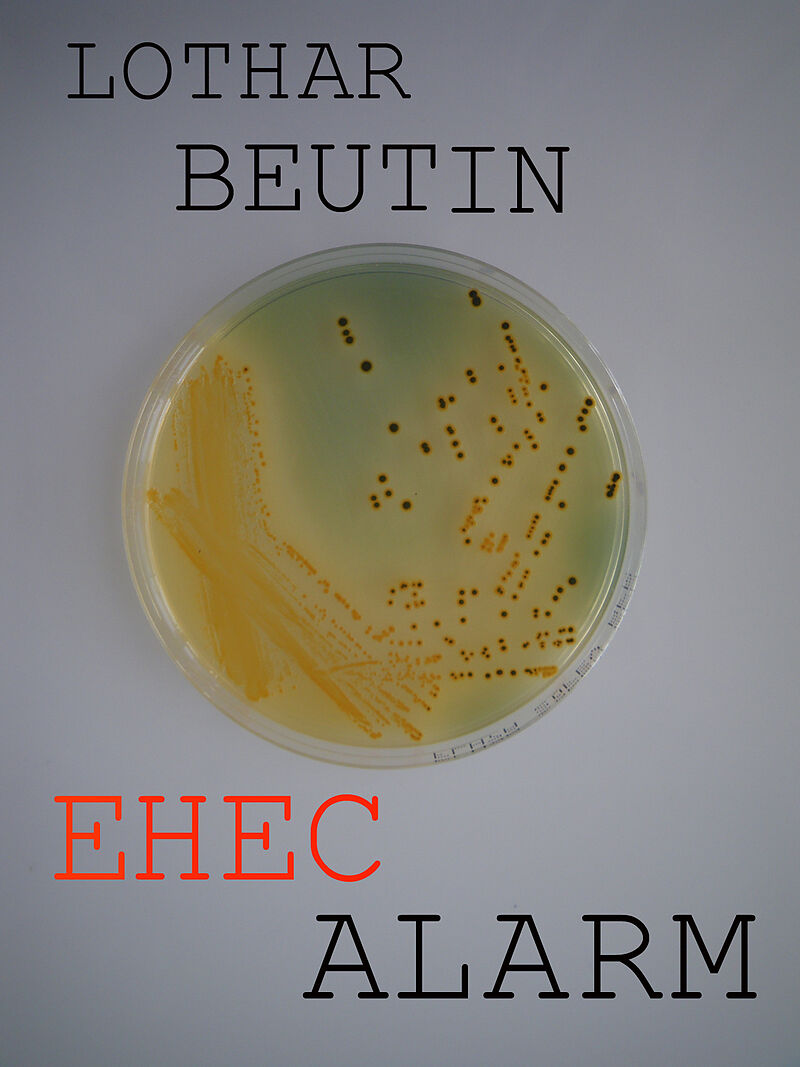
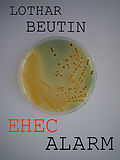

Beschreibung
Anfang Mai 2011 bricht in Deutschland eine Epidemie mit einem neuartigen Krankheitserreger auf: EHEC O104. Die EHEC-Bakterien verursachen blutigen Durchfall, in vielen Fällen sogar schwere Nierenschädigungen. Die meisten Opfer des EHEC-O104 sind jüngere, erwac...Anfang Mai 2011 bricht in Deutschland eine Epidemie mit einem neuartigen Krankheitserreger auf: EHEC O104. Die EHEC-Bakterien verursachen blutigen Durchfall, in vielen Fällen sogar schwere Nierenschädigungen. Die meisten Opfer des EHEC-O104 sind jüngere, erwachsene Frauen. In wenigen Wochen erkranken über viertausend Menschen und mehr als fünfzig von ihnen sterben an der Seuche. Die Epidemie verschwindet genauso plötzlich, wie sie gekommen ist. Erst werden verseuchte Gurken, dann Keimsprossen als Überträger der EHEC-Bakterien vermutet. Aber die wahre Herkunft der Seuche bleibt im Dunklen. Allmählich wird klar, was hinter der Seuche steckt. Ein genetisch manipuliertes Bakterium, dass absichtlich in die Umwelt gebracht wurde. Dr. Leo Schneider muss einen aussichtslos erscheinenden Kampf gegen einen skrupellosen Gegner führen, der auch vor Mord nicht zurückschreckt.
Autorentext
Lothar Beutin, geboren und aufgewachsen in Berlin, Mikrobiologe und Autor von Wissenschaftskriminal- und Gesellschaftsromanen. Langjährige Forschungstätigkeit in renommierten Berliner Instituten und am Institut Pasteur in Paris über Infektionskrankheiten, Lebensmittelvergiftungen und biologische Giftstoffe aller Art. Autor des 2011 erschienenen Romans RIZIN, eine Kriminalgeschichte um Biowaffenforschung, in der auch die Guten zwangsläufig zu Tätern werden. 2013 erschien sein Roman EHEC-ALARM, die Geschichte um einen kriminellen Hintergrund beim großen EHEC Ausbruch in Deutschland im Jahre 2011. Der jüngste, 2015 erschienene Roman FALLOBST, spielt in Berlin und in Frankreich, der zweiten Heimat des Autors. Es ist die Geschichte des Berliner Mikrobiologen Leo Schneider und seiner französische Kollegin Sandrine Martin. Beide kämpfen darum, in einem Klima von Lüge und Verrat der Wahrheit zum Sieg zu verhelfen, um einer kriminellen Bande von Alkoholpanschern und Lebensmittelvergiftern auf die Spur zu kommen.
Leseprobe
Die Handlung und die Personen in meinem Roman EHEC-Alarm sind fiktiv, seine Geschichte verläuft entlang der dramatischen Ereignisse, die sich in Deutschland im Sommer 2011 tatsächlich zugetragen haben. Anfang Mai 2011 bricht in Norddeutschland eine Epidemie mit einem in dieser Form noch nie da gewesenen Krankheitserreger aus: EHEC-O104. Die Zahl der infizierten Menschen steigt rasend schnell an, um in zwei Monaten eine Rekordhöhe von fast 4000 Erkrankten zu erreichen. Über die Hälfte der mit EHEC-O104 infizierten Menschen bekommen blutigen Durchfall, viele müssen stationär behandelt werden. Für fast neunhundert Patienten kommt es noch viel schlimmer. Sie erleiden eine Form der Nierenschädigung, die in der Medizin als Hämolytisch-Urämisches Syndrom (HUS) bezeichnet wird. HUS bedeutet für viele Betroffene lebenslange Nierenschäden und Abhängigkeit von regelmäßiger Blutwäsche durch Dialyse. Bei einem Teil der HUS-Patienten kommt es sogar zum vollständigen Verlust der Nierenfunktion. Dreiundfünfzig Menschen sterben an den Folgen der Seuche, die ihren Gipfel am 22. Mai erreicht und erst am 26. Juli 2011 für besiegt erklärt wird. Das hoch entwickelte deutsche Gesundheitssystem steht im Sommer 2011 vor seiner schlimmsten Krise seit Ende des Zweiten Weltkrieges. Die Versorgung der Patienten bringt die Krankenhäuser an den Rand der personellen und apparativen Belastbarkeit. In der Bevölkerung wächst die Unruhe über das ungehinderte Fortschreiten der EHEC-Seuche im gleichen Maße, wie ihre Herkunft, die Übertragung der Erreger und die Entwicklung der Epidemie weiterhin im Dunkeln bleiben. Zwar hatte es in Deutschland auch schon vor 2011 kleinere Ausbrüche mit anderen EHEC-Bakterien gegeben. Jedoch waren diese im Vergleich zur EHEC-O104 Seuche von 2011 unbedeutend. Die Epidemie von 2011 unterscheidet sich in vieler Hinsicht von allem, was vorher über EHEC bekannt war. Bei EHEC-O104 hat man es mit einem völlig neuen Erreger zu tun. Ein Killerbug, ein mörderisches Bakterium, das durch die Kombination von zwei bereits bekannten Krankheitserregern entstanden ist. Das Produkt dieser Kombination ist weitaus gefährlicher als die Vorläufer, aus denen das Killerbakterium zusammengesetzt ist. EHEC-O104 bringt alles mit sich, um den Menschen das Fürchten zu lehren. Der Keim ist gegen viele der modernsten Antibiotika resistent und hervorragend ausgestattet, den Verdauungstrakt des Menschen massiv zu besiedeln. Dazu produziert er ein starkes Zellgift (Shigatoxin-2), das für den blutigen Durchfall und die Nierenschäden verantwortlich ist. Die Kombination aller dieser Faktoren in ein und demselben Krankheitserreger ist neu. Bald schon wird darüber spekuliert, ob dieser Keim nicht das Produkt einer genetischen Manipulation sein könnte, beziehungsweise absichtlich in den Umlauf gebracht wurde. Diese Vorstellungen werden davon genährt, dass fast alles an dem EHEC-O104 nicht dem entspricht, was man vorher über EHEC wusste. Seine bevorzugten Opfer sind jüngere, erwachsene Frauen, die sich bewusst ernähren und keine gesundheitlichen Risikofaktoren aufweisen. Die Zeit zwischen der Ansteckung und dem tatsächlichen Ausbruch der Erkrankung ist außergewöhnlich lang. Mit der Folge, dass äußerlich gesunde, aber bereits infizierte Patienten als Ansteckungsquelle wochenlang mit anderen Menschen Kontakt haben. Aber das Merkwürdigste an EHEC-O104 ist die Tatsache, dass man ihn nicht dort findet, wo EHEC in der Natur sonst gewöhnlicherweise vorkommen. EHEC-Bakterien besiedeln natürlicherweise den Darmtrakt von Tieren, hauptsächlich Rinder und Schafe. EHEC-O104 findet man jedoch nicht bei Tieren, sein einziges bekanntes Reservoir ist der Mensch selbst. Viele dieser Merkwürdigkeiten sind bald nach Beginn der EHEC-O104 Epidemie bekannt. Umso dringender wird die Frage: Woher kommt diese Seuche? Die Suche nach der Herkunft des EHEC-O104 gestaltet sich zu einer Schnitzeljagd. Zuerst geraten spanische Gurken in Verdacht, mit dem Erreger verseucht zu sein. Eine Behauptung, die sich bald als haltlos erweist, aber da ist es bereits zu spät. In der Folge wird die europäische Landwirtschaft in eine ihrer tiefsten Krisen gestürzt. Der Absatz von Gurken und anderem Gemüse bricht zeitweilig völlig zusammen und Verluste von mehreren Hundert Millionen Euro sind zu verzeichnen. Nach den Gurken werden Keimsprossen, die aus einem Gartenbaubetrieb in Norddeutschland stammen, als Quelle des Ausbruchs vermutet. Jedoch werden, bis auf eine Ausnahme, keine EHEC-O104 aus den Keimsprossen isoliert. Nachdem die verdächtigen Keimsprossen vom Markt genommen sind und der Betrieb die Produktion eingestellt hat, geht die Zahl der Neuansteckungen rapide zurück. Der EHEC-Ausbruch endet wenige Wochen danach gänzlich. Woher die Seuche ursprünglich gekommen ist, bleibt bis heute im Dunklen. Die europäische Gesundheitsbehörde EFSA vermutet ihre Ursache in EHEC verseuchten Bockshornkleesamen, die aus Ägypten importiert und für die Produktion von Keimsprossen dienten. Die Einfuhr der Samen aus Ägypten wird sofort gestoppt. Jedoch werden die EHEC-O104 Erreger auch in den Bockshornkleesamen selbst nach intensiver Suche nicht gefunden. Bis heute ranken sich um einen der weltweit größten EHEC-Ausbrüche viele offen Fragen, die zu Spekulationen Anlass geben. Auch die Vorstellung, EHEC-O104 sei eine konstruierte Biowaffe und absichtlich auf Lebensmittel ausgebracht worden, ist eine der Hypothesen, die ins Spiel gebracht wurden. Genährt werden solche Vermutungen auch dadurch, weil eine absichtliche Kontamination eines Lebensmittels mit EHEC-Bakterien die gleichen Auswirkungen hätte, wie ihre ungewollte Verseuchung durch einen infizierten Menschen, der EHEC-Bakterien ausscheidet. Vor diesem Hintergrund spielt die Geschichte des Romans EHEC-Alarm. Berlin, im April 2013 Lothar Beutin
